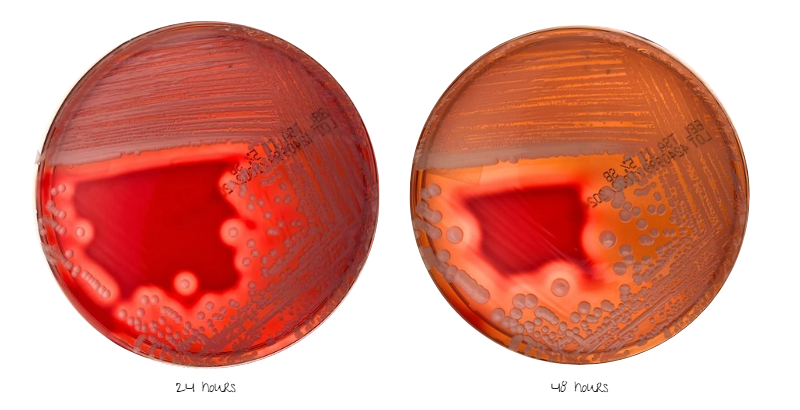
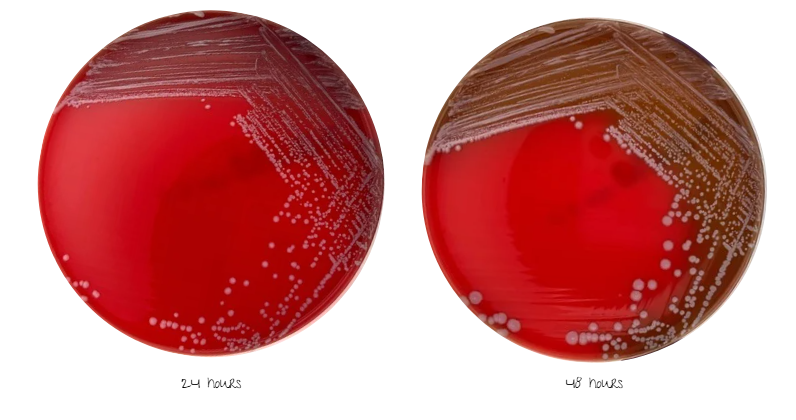
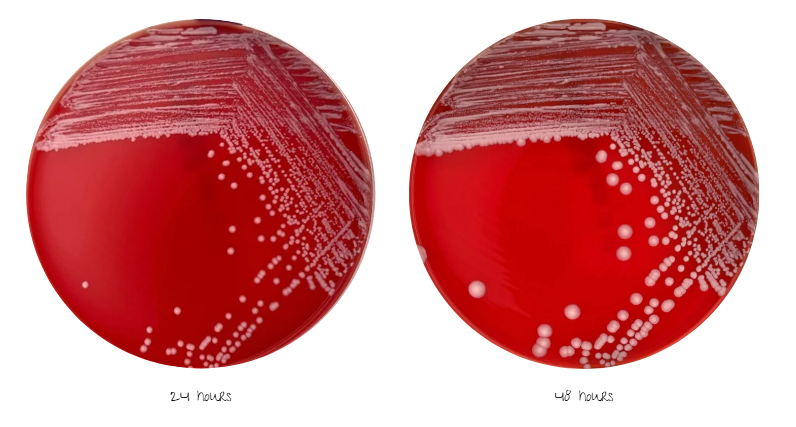
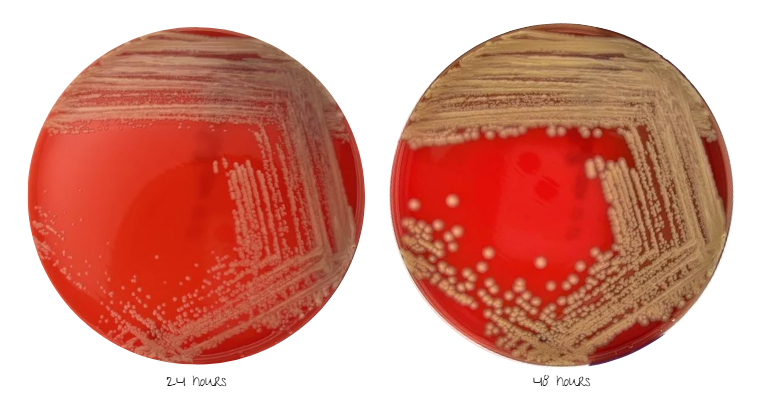
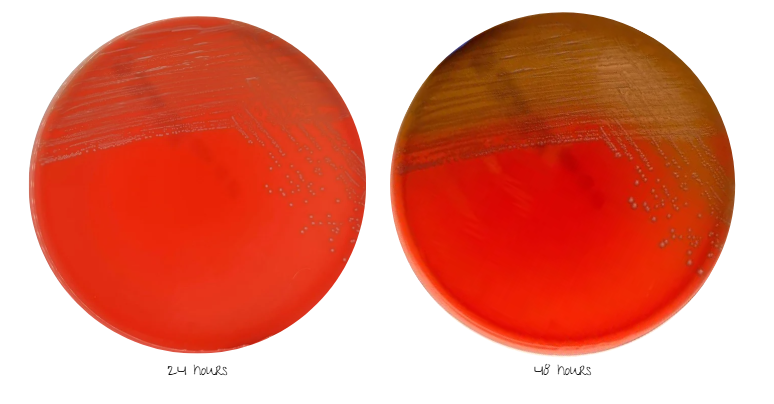
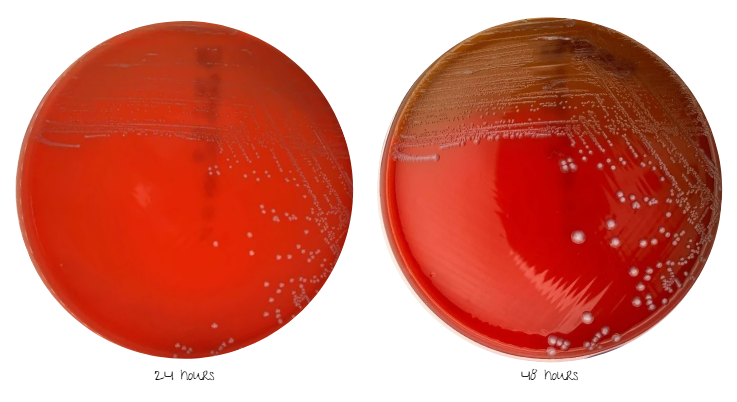
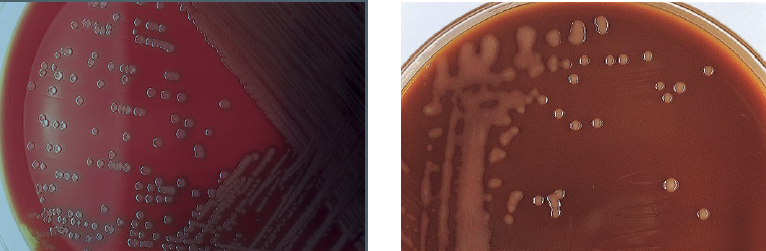
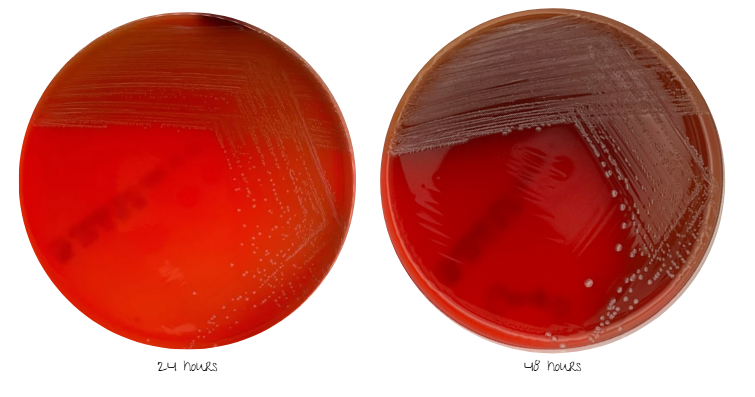
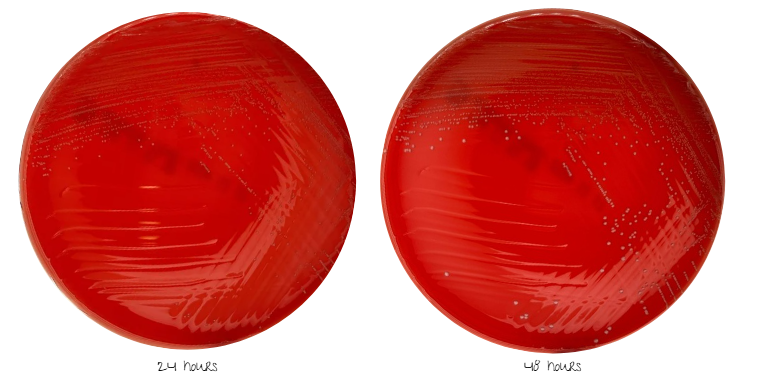
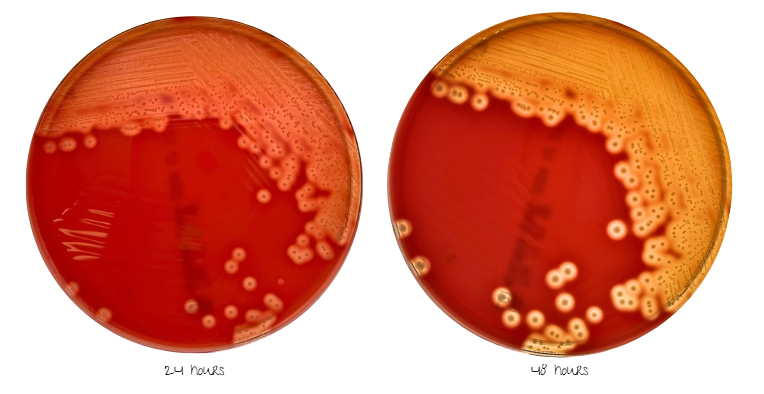

Gram Positive Organisms
White, Hemolytic
Staphylococcus aureus
Key Tests for Presumptive Identification
1. Catalase positive
2. Coagulase or Staphaurex postive

Very common pathogen seen in all sites, especially wound and skin infections.
Gram Positive Organisms
White, Nonhemolytic
Staphylococcus epidermidis
Key Tests for Minimal Morhological Identification (MMI)
1. Catalase positive
2. Coagulase/Staphaurex negative
MMI= Coagulase negative staphylococcus

Definitive ID achieved by MALDI-TOF
Associate w/ skin, common blood culture contaminant and foriegn device infections
Gram Positive Organisms
Bright White, Nonheme
Staphylococcus saprophyticus
Key Tests for Presumptive Identification
1. Catalase positive
2. Coagulase or Staphaurex postive
3. Novobiocin resistant

Associate w/ UTIs in young females
Gram Positive Organisms
Yellow
Micrococcus species
Key Tests for Presumptive Identification
1. Catalase positive
2. Coagulase or Staphaurex negative
3. Bacitracin susceptible

Associate with skin & environmental contamination
Gram positive organisms
Alpha
Enterococcus faecium
Key Tests for Minimal Morhological Identification (MMI)
1. Catalase negative
2. PYR positive
MMI= Enterococcus species

Definitive ID by MALDI-TOF or additional biochemicals
Associate E. faecium w/ VRE (vanA or vanB gene)
Gram Positive Organisms
Gamma
Enterococcus faecalis
Key Tests for Minimal Morhological Identification (MMI)
1. Catalase negative
2. PYR positive
MMI= Enterococcus species

Definitive ID by MALDI-TOF or additional biochemicals
Associate E. faecalis w/ VSE
Gram positive organisms
2 variations
Streptococcus pneumoniae
Key Tests for Presumptive Identification
1. Catalase negative
2. Optochin disk susceptible
3. Bile solubility positive

Most frequently associated w/ respiratory infections
Gamma
Streptococcus bovis group (Group D Streptococci)
Key Tests for Presumptive Identification
1. Catalase negative
2. PYR negative
3. Bile esculin positive

Colonizes the GI tract. Associate w/ bacteremia & endocarditis
Pinpoint alpha or pinpoint beta
S. anginosus group
Key Tests for Presumptive Identification
1. Catalase negative
2. VP positive
3. Arginine positive
4. Butterscotch smell

Associate w/ deep tissue abscess
Beta
Streptococcus pyogenes
Key Tests for Presumptive Identification
1. Catalase negative
2. Bacitracin disk susceptible
3. PYR positive

Associate w/ strep throat & soft tissue infections (including necrotizing fascitiis)


